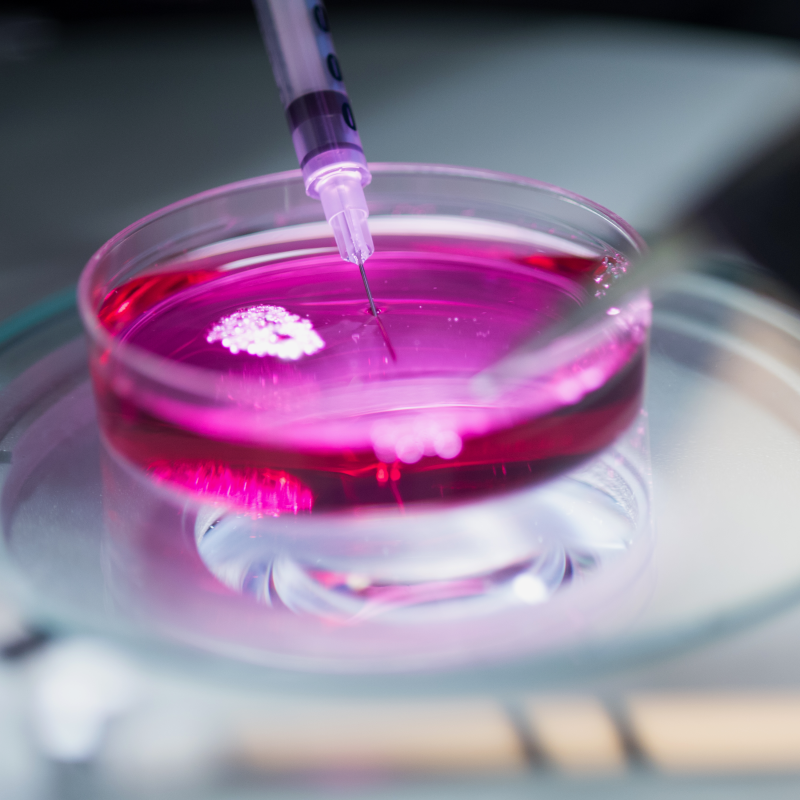
Preparation of cells in culture

With groundbreaking research, a strong and growing faculty, and modern facilities, the Biological Sciences Department at RPI trains students to tackle the complex biological challenges they will face in their careers at the cellular, molecular, and biophysical levels.